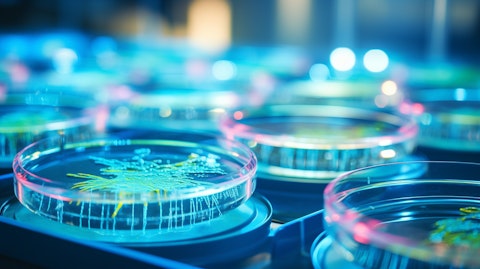
Is Nanobiotix (NBTX) the Best Nanotech Penny Stock to Invest In?

We recently published a list of 7 Best Nanotech Penny Stocks to Invest In. In this article, we are going to take a look at where Nanobiotix (NASDAQ:NBTX) stands against other best nanotech penny stocks to invest in.
Nanotech involves working with tiny particles which are about the size of molecules. This field is being used to improve products in many different industries, like electronics, medicine, and energy. By manipulating matter at this tiny scale, materials and devices with special properties can be made. The global nanotech market was valued at $3.69 billion in 2022 and is projected to grow at a 33.1% CAGR from 2023 to 2030, as reported by Grand View Research. This is driven by the increased use in medical diagnostics and imaging, technological advancements, substantial R&D funding, and the creation of advanced materials for healthcare, electronics, aerospace, textiles, transportation, manufacturing, and agriculture.
In 2022, nanodevices dominated the nanotech market, accounting for over 58% of global revenue. This was due to their potential in healthcare (targeted drug delivery, imaging, diagnostics, regenerative medicine) and electronics (smaller transistors, memory devices, sensors). Nanosensors, which are crucial for nanoscale detection and measurement across many industries, are projected to grow. Healthcare and pharmaceuticals led applications in 2022, with over 26% market share. This was driven by the increased use of nanotech in areas like surgical nano-robots, nano-diagnostics, and targeted drug delivery, as well as rising chronic disease prevalence and surgical procedures. The automobile segment is also expected to grow due to nanotech’s improvements in materials, energy efficiency, safety, and functionality.
While the nanotech industry as a whole holds promise, it is still in its early innings and many companies are in the small-cap territory.
Methodology
We first sifted through ETFs, online rankings, and internet lists to compile a list of the top nanotech stocks under $5. We then selected the 7 stocks that were the most popular among elite hedge funds and that analysts were bullish on. The stocks are ranked in ascending order of the number of hedge funds that have stakes in them, as of Q3 2024. The hedge fund data was sourced from Insider Monkey’s database which tracks the moves of over 900 elite money managers.
Why are we interested in the stocks that hedge funds pile into? The reason is simple: our research has shown that we can outperform the market by imitating the top stock picks of the best hedge funds. Our quarterly newsletter’s strategy selects 14 small-cap and large-cap stocks every quarter and has returned 275% since May 2014, beating its benchmark by 150 percentage points (see more details here).
A close-up of a Petri dish in a laboratory filled with biological cultures related to the company’s product.
Nanobiotix (NASDAQ:NBTX)
Number of Hedge Fund Holders: 1
Share Price as of February 11: $3.9
Nanobiotix (NASDAQ:NBTX) is a clinical-stage nanomedicine company that develops nanoparticle-based cancer treatments. Its core focus is the NBTXR3 nanomedicine platform. This technology centers around functionalized hafnium oxide nanoparticles designed for direct tumor injection. This enhances radiotherapy for various cancers, which include soft tissue sarcoma and head and neck cancers.
Once injected, these nanoparticles are activated by radiotherapy, which triggers significant tumor cell death at the targeted site. This localized cell death is believed to stimulate a broader and systemic anti-cancer immune response. NBTXR3 is currently being investigated across a range of solid tumor types. These include head and neck cancers, pancreatic cancer, and lung cancer. The therapy is being evaluated as a standalone treatment and in combination with immune checkpoint inhibitors.
A study is the ongoing Phase 3 NANORAY-312 trial which targets head and neck cancer. This is a step towards regulatory submission and eventual commercialization. The company has partnered with Janssen (a global licensee) for the global co-development and commercialization of NBTXR3. Financially, as of September 30, 2024, Nanobiotix (NASDAQ:NBTX) reported €53.2 million in cash and cash equivalents. This funding will support operations into the fourth quarter of 2025.
Overall, NBTX ranks 6th on our list of best nanotech penny stocks to invest in. While we acknowledge the growth potential of NBTX, our conviction lies in the belief that AI stocks hold great promise for delivering high returns and doing so within a shorter timeframe. If you are looking for an AI stock that is more promising than NBTX but that trades at less than 5 times its earnings, check out our report about the cheapest AI stock.
READ NEXT: 20 Best AI Stocks To Buy Now and Complete List of 59 AI Companies Under $2 Billion in Market Cap
Disclosure: None. This article is originally published at Insider Monkey.




